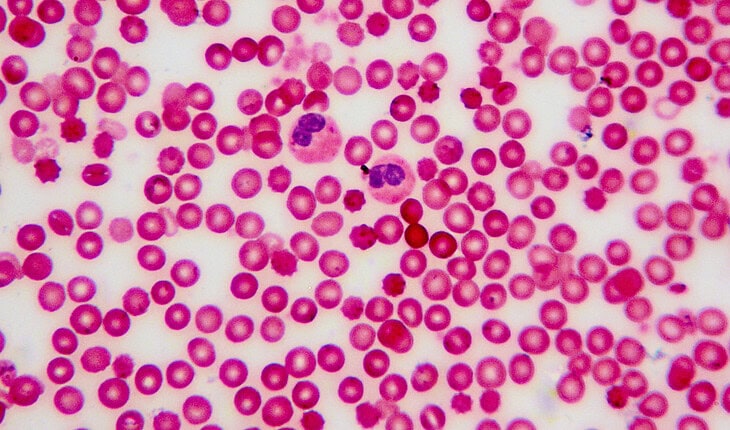

Improving blood culture diagnostics across the NHS
IBMS, BD and PLMR Healthcomms have released a new paper, Lost in the Bloodstream – A Holistic Approach to Blood Culture Improvement, which brings together the experiences and insights of NHS professionals across the blood culture pathway. Based on national FOI data and in-depth interviews, the report highlights the need for more consistent and collaborative approaches to reduce contamination rates, improve diagnostic accuracy and enhance patient care.
Blood culture tests are a critical part of diagnosing bloodstream infections. However, delays, variation in practice, and high contamination rates can lead to misdiagnosis, inappropriate treatment and increased patient risk.
Drawing on the experiences of NHS clinical leaders and pathology professionals, the report outlines a series of interventions to improve performance across the full pathway — from test ordering and sample collection to laboratory analysis and clinical communication.
Key recommendations include:
Standardising collection and handling procedures: Improving training, protocols and technology to reduce contamination and ensure reliable samples.
Improving system-wide collaboration: Supporting joined-up working between clinical and pathology teams to improve decision-making and streamline the diagnostic process.
Using data to drive quality improvement: Monitoring performance, sharing learning and embedding continuous improvement within local services.
David Wells, Chief Executive of the IBMS, said:
“Blood culture testing is a vital part of infection diagnosis, the timely delivery of blood cultures saves lives and improves AMR stewardship. Improving the pathway requires not just technical solutions but system-wide collaboration — from the ward to the lab. This report highlights how better practice and joined-up working can protect patients and support clinical teams.”
Matthew Spencer, Account Director at PLMR Healthcomms, said:
“To fully understand the opportunities and challenges that clinical leaders encounter in implementing innovation within the blood cultures pathway, it is essential that we listen directly to their experiences. We hope that this report will provide a useful guide to support NHS leaders to learn from examples of best practice across the NHS, to drive improvements in the delivery of local patient care.”
Greg Quinn, Director, Public Policy & Advocacy UKI at BD, said:
“BD has been an integral part of the IMC since its inception, aligning perfectly with our mission in Advancing The world of health and emphasize antimicrobial stewardship. To develop a meaningful plan for the NHS to address infection challenges and identify areas where BD can support the system, we partnered with PLMR Healthcomms to conduct a detailed analysis of current practices within the NHS, specifically focusing on blood cultures. Based on these insights, BD and PLMR have formulated clear, straightforward recommendations to establish standardized best practices across the system, concentrating on blood volume and time to instrument. Since the publication of this report, it has been encouraging to witness the progress made by both laboratories and clinical areas in improving practices and prioritizing patient outcomes.”
The full report Lost in the Bloodstream – A Holistic Approach to Tackling the Blood Culture Improvement is available now.
- 2026 QE Prize - 6th February 2026
- A video game to learn medicine - 30th January 2026
- AI chatbots could help curb risky drinking - 30th January 2026